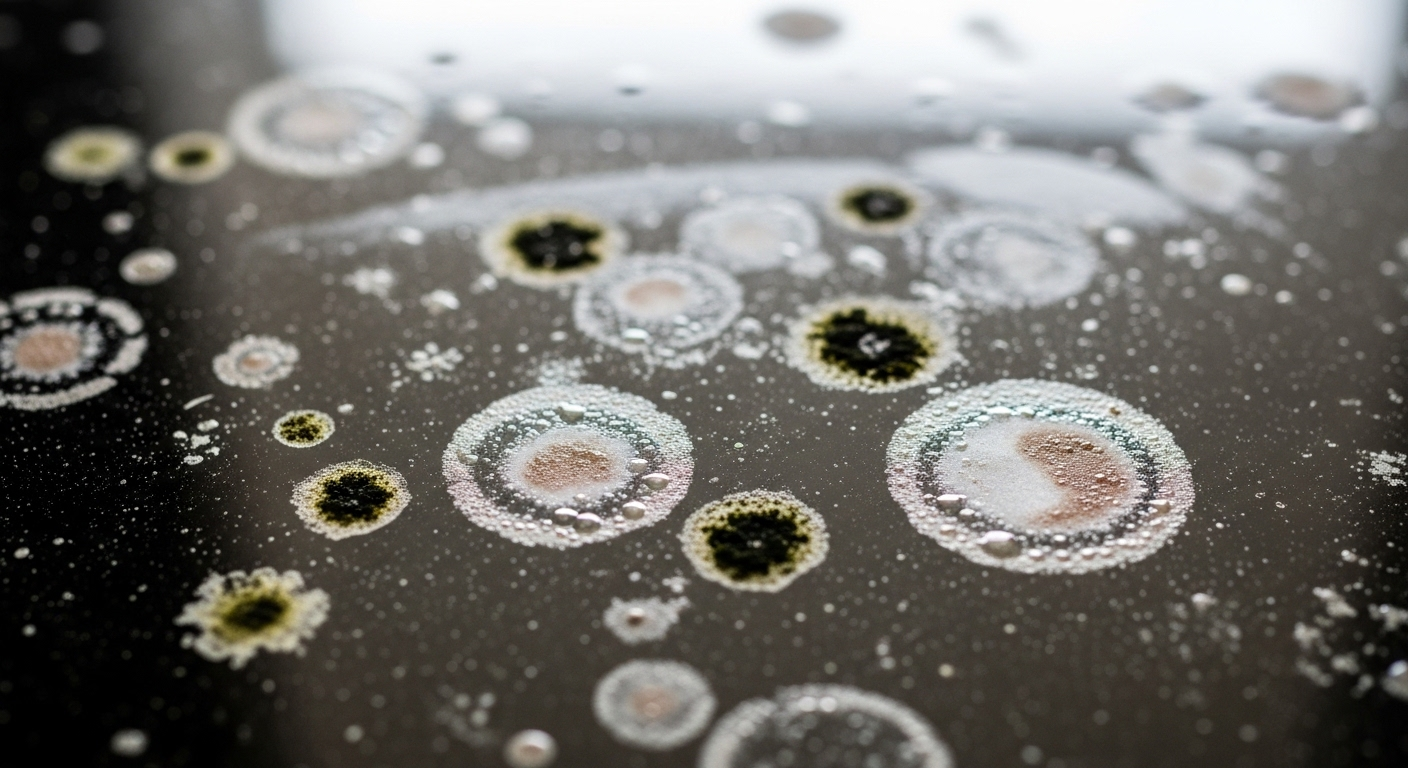
Cận cảnh mặt gương bẩn với vết nước cứng đầu hình tròn, đốm ố mốc và dấu vân tay mờ, nhấn mạnh nhu cầu tìm cách lau gương sạch hiệu quả. Cận cảnh mặt gương bẩn với vết nước cứng đầu hình tròn, đốm ố mốc và dấu vân tay mờ, nhấn mạnh nhu cầu tìm cách lau gương sạch hiệu quả.

1. Khám Phá Nguyên Nhân Gương Bị Ố Mờ, Không Sáng Bóng
Tại sao gương thường xuyên bị bám bẩn và mờ đi?
Nhiều bạn cứ thắc mắc sao gương nhà mình cứ nhanh bị ố mờ, dù có lau cách mấy cũng không thể sáng bóng như ban đầu. Thực ra, nguyên nhân thì có nhiều, và hiểu rõ chúng sẽ giúp chúng ta có cách lau gương sạch hiệu quả hơn.
-
Chất lượng gương: Đây là yếu tố đầu tiên phải kể đến. Gương giá rẻ thường có lớp tráng kém chất lượng, dễ bị oxy hóa và xuống cấp nhanh hơn, khả năng chống bám bẩn hay ố vàng cũng chẳng được bao nhiêu.
-
Môi trường ẩm ướt: Ai cũng biết gương phòng tắm là “nạn nhân” số một. Hơi nước nóng, cặn xà phòng, dầu gội… cứ thế bám vào, tạo thành những mảng mờ khó chịu. Khu vực có độ ẩm cao lúc nào cũng dễ làm gương bị ố vàng hơn cả.
-
Sử dụng hóa chất không đúng cách: Không phải cứ hóa chất mạnh là tốt. Nhiều loại nước lau kính kém chất lượng, đặc biệt là những loại chứa amoniac nồng độ cao, về lâu dài sẽ bào mòn, làm hỏng lớp tráng gương, khiến nó mất đi vẻ sáng bóng tự nhiên.
-
Không vệ sinh định kỳ: Bụi bẩn, dầu mỡ từ tay hay không khí cứ tích tụ từng chút một. Để lâu ngày, chúng sẽ kết thành lớp bẩn cứng đầu, càng khó làm sạch.
-
Ảnh hưởng từ khí hậu: Với khí hậu nóng ẩm như ở Việt Nam, nấm mốc và vi khuẩn rất thích “định cư” trên bề mặt gương, đặc biệt là ở những nơi ít thông thoáng, góp phần làm gương nhanh chóng xuống cấp.
Các loại vết bẩn cứng đầu thường gặp trên gương
Khi đối mặt với gương bị ố vàng, chúng ta thường gặp phải vài loại “kẻ thù” quen mặt:
-
Vết nước cứng, cặn xà phòng: Đây là loại phổ biến nhất, đặc biệt ở gương phòng tắm. Chúng tạo thành những mảng trắng đục, lì lợm.
-
Ố vàng do nấm mốc: Những đốm đen li ti hoặc mảng ố vàng do môi trường ẩm thấp gây ra.
-
Vết sơn, mực, keo dán: Những vết bẩn này thường là “tai nạn” bất ngờ, cần phương pháp xử lý đặc biệt.
-
Dấu vân tay, bụi bẩn thông thường: Mặc dù dễ lau hơn, nhưng nếu không được xử lý kịp thời, chúng cũng góp phần làm gương mất đi vẻ đẹp vốn có.
2. Chuẩn Bị Toàn Diện Cho Công Cuộc Vệ Sinh Gương Hiệu Quả
Dụng cụ và vật liệu cần có trước khi bắt đầu
Để việc làm sạch gương diễn ra suôn sẻ, chuẩn bị là yếu tố then chốt. Đừng để đến lúc bắt tay vào làm mới chạy đi tìm đồ, mất công lắm bạn ạ!
-
Khăn mềm sợi microfiber: Đây là “vũ khí” quan trọng nhất. Ưu tiên có hai chiếc: một để thấm dung dịch lau và một chiếc khô ráo để lau lại, đảm bảo gương không bị vệt.
-
Bình xịt rỗng: Để pha chế các dung dịch tự nhiên, tiện lợi khi xịt lên gương.
-
Chổi cao su chuyên dụng: Nếu bạn muốn gương sáng bóng không tì vết, không một vệt nước nào, thì đây là lựa chọn tuyệt vời (tùy chọn).
-
Xô hoặc chậu nước: Để chứa nước sạch hoặc dung dịch pha loãng.
-
Găng tay bảo hộ: Rất cần thiết khi bạn sử dụng các loại hóa chất tẩy rửa mạnh, để bảo vệ da tay.

Bộ dụng cụ chuẩn bị cho cách lau gương sạch hiệu quả, gồm khăn microfiber, bình xịt, cây gạt nước, giấm trắng và lát chanh tươi, sắp xếp gọn gàng trên mặt bàn.
Nguyên tắc vàng giúp lau gương sạch bóng không tì vết
Làm gì cũng có “bí kíp” riêng, lau gương cũng vậy. Nắm vững những nguyên tắc này, bạn sẽ thấy việc làm sạch trở nên dễ dàng hơn nhiều.
-
Lau từ trên xuống dưới: Luôn bắt đầu từ mép trên cùng của gương và di chuyển xuống dưới. Điều này giúp tránh việc nước bẩn chảy ngược xuống các khu vực đã lau, gây ra vệt.
-
Sử dụng khăn sạch và khô ráo: Một chiếc khăn bẩn hoặc ẩm ướt sẽ chỉ làm gương thêm mờ. Hãy đảm bảo khăn của bạn luôn trong tình trạng tốt nhất.
-
Tránh dùng quá nhiều dung dịch tẩy rửa: Một lượng vừa đủ là đủ. Quá nhiều dung dịch không những không sạch hơn mà còn dễ để lại vệt và khó lau khô.
-
Vệ sinh ngay khi phát hiện vết bẩn: “Phòng bệnh hơn chữa bệnh” là đúng trong trường hợp này. Vết bẩn càng mới càng dễ xử lý. Để lâu, chúng sẽ “ăn sâu” hơn và khó khăn hơn khi tìm cách lau gương sạch.
-
Đảm bảo thông gió tốt: Đặc biệt khi dùng hóa chất, hãy mở cửa sổ hoặc bật quạt để không khí lưu thông, tránh hít phải mùi khó chịu.
3. Hơn 20 Phương Pháp Lau Gương Sáng Bóng Như Mới Tại Nhà
Đã đến phần quan trọng nhất đây rồi! Với kinh nghiệm của mình, tôi đã tổng hợp những mẹo lau gương hiệu quả nhất, từ tự nhiên đến các sản phẩm gia dụng, thậm chí cả những giải pháp mạnh tay hơn.
Tận dụng sức mạnh từ nguyên liệu tự nhiên và quen thuộc
Nếu bạn ngại dùng hóa chất hay chỉ muốn xử lý vết ố nhẹ, đây là những lựa chọn an toàn và thân thiện.
-
Giấm trắng:
- Cách làm: Pha giấm với nước ấm theo tỉ lệ 1:1 trong bình xịt. Xịt đều lên gương và dùng khăn mềm lau sạch.
- Lưu ý: Giấm rất hiệu quả với các vết ố mờ, cặn xà phòng và thậm chí cả vết sơn nhỏ. An toàn cho hầu hết các loại gương.
-
Muối trắng:
- Cách làm: Gói một ít muối vào khăn ẩm, chà nhẹ lên những vết ố lâu ngày. Hoặc bạn có thể pha muối với nước cốt chanh hay một ít sữa bò để tăng cường hiệu quả.
- Lưu ý: Muối có tính mài mòn nhẹ, giúp đánh bật vết bẩn cứng đầu nhưng cần chà nhẹ tay để tránh làm xước gương.
-
Chanh (kết hợp muối):
- Cách làm: Trộn nước cốt chanh với muối hạt theo tỉ lệ 2:1 để tạo thành hỗn hợp sệt. Thoa lên vết bẩn, dùng bàn chải mềm cọ nhẹ, để khoảng 5 phút rồi rửa sạch bằng nước.
- Lưu ý: Chanh có axit tự nhiên giúp tẩy rửa và chống oxy hóa. Đặc biệt phù hợp với vết bẩn có tính bazo.
-
Bột bắp (bột ngô):
- Cách làm: Một công thức “thần thánh” mà ít ai biết. Pha 2 thìa bột bắp với ½ chén giấm và 3 lít nước. Cho vào bình xịt, xịt lên gương rồi lau sạch bằng khăn microfiber.
- Lưu ý: Bột bắp giúp gương sáng bóng không tì vết, không để lại sợi vải hay vệt nước.

Gương trong suốt, sáng bóng không vệt ố trong phòng tắm hiện đại, phản chiếu đèn rõ nét – minh chứng cho cách lau gương sạch hiệu quả. -
Sữa bò:
- Cách làm: Dùng khăn mềm nhúng vào sữa bò ấm, vắt bớt nước rồi lau đều khắp bề mặt gương. Sau đó, lau lại bằng nước sạch và khăn khô. Với vết ố cứng đầu, có thể thêm chút muối vào sữa.
- Lưu ý: Sữa bò là phương pháp dịu nhẹ, an toàn và giúp gương có độ bóng tự nhiên.
-
Nước ấm đơn thuần:
- Cách làm: Đơn giản nhất là dùng khăn mềm nhúng nước ấm, vắt thật ráo rồi lau nhẹ nhàng.
- Lưu ý: Chỉ hiệu quả với các vết mờ nhẹ, bụi bẩn thông thường. Không đủ mạnh cho vết ố lâu ngày.
Làm sạch gương bằng sản phẩm gia dụng tiện lợi
Những món đồ quen thuộc trong bếp hoặc phòng tắm cũng có thể là những trợ thủ đắc lực trong việc tìm cách lau gương sạch.
-
Nước rửa chén:
- Cách 1: Pha vài giọt nước rửa chén với nước sạch, dùng khăn mềm thấm dung dịch và lau.
- Cách 2: Pha nước rửa chén, giấm và nước sạch theo tỉ lệ 1:1:3 giọt để tăng cường hiệu quả tẩy rửa.
- Cách 3: Pha 5 giọt nước rửa chén với một chai nước ngọt có ga nhỏ. Sự kết hợp này tạo ra một dung dịch tẩy rửa mạnh mẽ bất ngờ.
- Lưu ý: Nước rửa chén rất dễ tìm và hiệu quả với nhiều loại vết bẩn từ dầu mỡ đến bụi bẩn.
-
Kem đánh răng:
- Cách làm: Xịt một lượng nhỏ kem đánh răng lên vết ố hoặc mảng mờ, dùng khăn mềm chà nhẹ theo hình tròn. Sau đó lau sạch bằng khăn ẩm.
- Lưu ý: Tuyệt vời để xử lý các vết ố nhỏ, mờ do nước cứng hoặc dấu vân tay. Không nên dùng quá nhiều.
-
Baking soda (kết hợp muối, nước rửa bát):
- Cách làm: Trộn đều baking soda, muối hạt và vài giọt nước rửa chén để tạo thành hỗn hợp sệt. Thoa lên kính, chà nhẹ bằng bàn chải mềm hoặc khăn, để khoảng 15 phút rồi rửa sạch bằng nước.
- Lưu ý: Đây là một công thức mạnh mẽ hơn, rất hữu ích cho các vết bẩn cứng đầu hoặc gương bị ố vàng nặng.
-
Nước xả quần áo:
- Cách làm: Pha dung dịch nước xả quần áo với nước sạch theo tỉ lệ 1:4. Dùng khăn vải mềm hoặc nhung thấm dung dịch và lau gương.
- Lưu ý: Không chỉ giúp gương sáng bóng mà còn để lại mùi thơm dễ chịu. Tuy nhiên, chỉ nên dùng cho vết bẩn nhẹ.
Cận cảnh mặt gương bẩn với vết nước cứng đầu hình tròn, đốm ố mốc và dấu vân tay mờ, nhấn mạnh nhu cầu tìm cách lau gương sạch hiệu quả. -
Nước ngọt có ga (Coca-cola hoặc tương tự):
- Cách làm: Xịt trực tiếp nước ngọt lên gương, để khoảng 1-2 phút cho axit nhẹ trong nước ngọt phát huy tác dụng. Sau đó lau lại bằng khăn sạch và nước.
- Lưu ý: Axit phosphoric trong nước ngọt có thể giúp đánh bay vết bẩn, nhưng cần lau lại kỹ để tránh đường trong nước ngọt làm gương bị dính.
Giải pháp làm sạch chuyên sâu với hóa chất thông dụng
Đôi khi, các vết bẩn cứng đầu cần đến “đòn bẩy” mạnh hơn. Hãy cẩn thận khi dùng những dung dịch này nhé.
-
Cồn, dầu hỏa, xăng, rượu trắng:
- Cách làm: Đổ một ít dung dịch lên khăn mềm (chỉ một lượng nhỏ thôi!), lau trực tiếp lên những vết bẩn “cứng đầu” nhất như mực, keo, sơn, hoặc các mảng mốc bám dai dẳng.
- Lưu ý:
- Những chất này có mùi khá mạnh, nên hãy đảm bảo không gian thông gió thật tốt.
- Sau khi lau vết bẩn, bạn nên lau lại gương bằng xà phòng và nước sạch để loại bỏ mùi và cặn hóa chất.
- Tránh để da tiếp xúc trực tiếp với hóa chất.
-
Dung dịch tẩy sơn móng tay (Acetone):
- Cách làm: Nhỏ vài giọt acetone vào một miếng bông hoặc khăn ẩm, nhẹ nhàng lau lên vết bẩn mà nước thường không thể tẩy đi được.
- Lưu ý: Acetone rất hiệu quả với các vết bẩn gốc dầu, keo dán. Tuy nhiên, cần dùng cẩn thận, tránh để dung dịch dây vào khung gương (đặc biệt là khung gỗ hoặc sơn) vì có thể làm hỏng bề mặt.
Mẹo làm sạch hiệu quả với dụng cụ đơn giản
Đừng coi thường những vật dụng tưởng chừng bỏ đi, chúng có thể là bí quyết để có cách lau gương sạch mà bạn không ngờ đấy.
-
Giấy báo cũ:
- Cách 1: Xịt nước sạch lên gương, sau đó dùng giấy báo vo tròn và lau đều.
- Cách 2: Sử dụng nước lau kính chuyên dụng, rồi dùng giấy báo vo tròn để lau lại.
- Lưu ý: Giấy báo có khả năng thấm hút tốt và không để lại sợi vải như khăn. Tuy nhiên, bạn nên lau lại bằng khăn sạch để loại bỏ bụi báo còn sót lại.
-
Cát:
- Cách làm: Với những vết vôi, sơn tường bám chặt trên gương, bạn có thể dùng khăn ướt chấm một ít cát mịn, chà nhẹ nhàng lên vết bẩn.
- Lưu ý: Đây là mẹo chỉ dùng cho những vết bẩn đặc biệt, cực kỳ cứng đầu. Bạn phải cực kỳ cẩn thận và nhẹ tay để tránh làm xước bề mặt gương.

Cận cảnh cây gạt nước đang gạt trên mặt gương ướt, để lộ bề mặt sáng bóng không vệt. Minh họa cách lau gương sạch. -
Chổi cao su lau kính:
- Cách làm: Nhúng chổi vào xô nước nóng đã pha một chút nước rửa chén. Làm ướt đều bề mặt gương, sau đó dùng chổi cao su đẩy nhẹ nhàng từ trên xuống dưới theo một đường thẳng, chồng lên nhau một chút sau mỗi lần đẩy.
- Lưu ý: Đây là phương pháp chuyên nghiệp, hiệu quả cao, giúp gương không bị vệt và sáng bóng nhanh chóng.
4. Bí Quyết Giữ Gương Luôn Sáng Bóng và Hạn Chế Ố Mờ Dài Lâu
Làm sạch đã khó, giữ cho gương luôn sạch còn khó hơn. Nhưng đừng lo, có những bí quyết nhỏ mà tôi đã đúc kết được để bạn giữ cho gương nhà mình luôn long lanh.
Thói quen vệ sinh gương định kỳ hiệu quả
-
Lau gương hàng ngày/tuần: Dùng khăn ẩm mềm lau nhẹ nhàng để loại bỏ bụi bẩn mới bám vào. Điều này giúp ngăn chặn chúng tích tụ và trở thành vết bẩn cứng đầu.
-
Vệ sinh sâu hơn mỗi tháng/quý: Mỗi tháng hoặc mỗi quý, hãy dành thời gian vệ sinh gương kỹ lưỡng hơn bằng các phương pháp tự nhiên hoặc sản phẩm gia dụng đã đề cập ở trên. Đây là cách giúp gương sáng bóng và bền đẹp theo thời gian.
Mẹo ngăn ngừa ố mờ, nấm mốc quay trở lại
Phòng bệnh hơn chữa bệnh luôn là lời khuyên đúng đắn, đặc biệt với gương.
-
Đảm bảo thông gió tốt cho phòng tắm: Luôn bật quạt hút mùi hoặc mở cửa sổ sau khi tắm. Hơi nước là kẻ thù số một của gương.
-
Lau khô gương sau khi tắm: Chỉ mất vài giây để dùng khăn sạch lau khô gương sau khi tắm, nhưng nó sẽ giúp bạn tránh được rất nhiều cặn xà phòng và hơi nước tích tụ.
-
Sử dụng lớp phủ chống bám hơi nước/chống ố: Một số sản phẩm trên thị trường có thể tạo một lớp màng mỏng trên gương, giúp chống bám hơi nước và giảm sự hình thành vết ố.
Lựa chọn chất liệu gương chất lượng ngay từ đầu
Nếu bạn đang có ý định mua gương mới, hãy đầu tư một chút vào chất lượng. Gương tốt sẽ giúp bạn tiết kiệm rất nhiều công sức về sau.
-
Đầu tư vào gương có khả năng chống ố, chống bám hơi nước: Tìm hiểu các loại gương từ nhà cung cấp uy tín, có công nghệ phủ đặc biệt.
-
Tìm hiểu về lớp tráng bạc, tráng đồng: Những lớp tráng này không chỉ mang lại độ phản chiếu tốt mà còn có khả năng chống oxy hóa, giúp gương bền hơn và ít bị ố vàng.
5. Khi Nào Cần Tìm Đến Các Giải Pháp Chuyên Nghiệp?
Mặc dù chúng ta có rất nhiều mẹo lau gương tại nhà, nhưng đôi khi, vấn đề vượt quá khả năng xử lý của cá nhân. Đó là lúc bạn cần nghĩ đến sự hỗ trợ từ các chuyên gia.
Dấu hiệu nhận biết gương cần chuyên gia xử lý
-
Vết ố vàng, ố mốc ăn sâu: Những vết ố đã “ăn sâu” vào lớp tráng gương, không thể làm sạch bằng bất kỳ phương pháp tự nhiên hay hóa chất thông thường nào.
-
Gương bị xước, hỏng lớp tráng bạc: Nếu gương đã xuất hiện những vết xước sâu hoặc lớp tráng bạc bên trong bị bong tróc, bạc màu, thì việc lau chùi chỉ là tạm thời, cần phải phục hồi hoặc thay thế.
-
Diện tích gương quá lớn hoặc vị trí khó tiếp cận: Gương tường lớn, gương trên cao hoặc gương có thiết kế phức tạp có thể gây khó khăn và nguy hiểm khi tự vệ sinh.

Lợi ích của việc vệ sinh gương chuyên nghiệp
Đừng ngại chi tiền cho dịch vụ chuyên nghiệp khi cần, những lợi ích mang lại rất xứng đáng.
-
Sử dụng hóa chất và công nghệ chuyên dụng: Các đơn vị chuyên nghiệp có những loại hóa chất và thiết bị đặc biệt mà chúng ta khó có thể tìm mua ở nhà, giúp làm sạch triệt để và an toàn.
-
Đảm bảo an toàn cho bề mặt gương và khung: Họ biết cách xử lý từng loại gương, từng loại vết bẩn mà không làm hỏng bề mặt hay khung gương.
-
Tiết kiệm thời gian và công sức: Bạn sẽ không phải vật lộn hàng giờ liền với những vết bẩn cứng đầu.
-
Khắc phục triệt để các vấn đề cứng đầu: Chuyên gia có kinh nghiệm để xử lý mọi vấn đề, từ vết ố mốc nặng đến việc phục hồi độ bóng cho gương.
6. Tránh Những Sai Lầm Phổ Biến Khi Lau Gương Tại Nhà
Trong hành trình tìm kiếm cách lau gương sạch, đôi khi chúng ta mắc phải những sai lầm tưởng chừng nhỏ nhặt nhưng lại gây ra hậu quả không mong muốn. Tránh được những điều này, việc vệ sinh gương của bạn sẽ hiệu quả hơn rất nhiều.
Sử dụng khăn không phù hợp:
-
Dùng khăn bông cũ, khăn có lông: Những loại khăn này dễ để lại sợi vải li ti trên bề mặt gương, khiến gương trông bẩn hơn và tạo ra các vệt nước khó chịu.
-
Lời khuyên: Luôn ưu tiên sử dụng khăn sợi microfiber sạch, hoặc giấy báo cũ. Chúng có khả năng thấm hút tốt và không để lại cặn bẩn.
Lạm dụng hoặc dùng sai hóa chất tẩy rửa:
-
Sử dụng hóa chất quá mạnh làm hỏng lớp tráng gương: Một số hóa chất tẩy rửa mạnh, đặc biệt là loại chứa amoniac hoặc axit nồng độ cao, có thể bào mòn hoặc làm hỏng lớp tráng bạc của gương theo thời gian, khiến gương bị ố vàng vĩnh viễn.
-
Pha trộn các loại hóa chất không tương thích gây phản ứng phụ: Việc pha trộn tùy tiện các hóa chất khác nhau có thể tạo ra phản ứng không mong muốn, vừa độc hại cho sức khỏe, vừa làm hỏng gương.
-
Lời khuyên: Đọc kỹ hướng dẫn sử dụng của sản phẩm. Nếu bạn muốn thử một hóa chất mới hoặc một công thức tự chế, hãy thử nghiệm ở một góc khuất nhỏ của gương trước để đảm bảo an toàn.
Bỏ qua việc vệ sinh khung gương và các chi tiết xung quanh:
-
Gương chỉ sạch khi các phần xung quanh cũng sạch: Bụi bẩn, nước đọng ở khung gương có thể chảy ngược xuống bề mặt khi bạn lau, hoặc khiến tổng thể trông không được sạch sẽ.
-
Lời khuyên: Hãy nhớ lau chùi cả khung gương và các phụ kiện gắn kèm như viền, giá đỡ. Điều này không chỉ giúp gương sạch hơn mà còn kéo dài tuổi thọ của chúng.
7. Tạm Kết: Tự Tin Giữ Gương Luôn Sáng Bóng Tại Gia
Qua những chia sẻ chân thành từ kinh nghiệm của mình, tôi hy vọng bạn đã bỏ túi được kha khá mẹo và cách lau gương sạch bóng như mới ngay tại nhà. Gương không chỉ là vật dụng phản chiếu hình ảnh mà còn góp phần tạo nên vẻ đẹp, sự thông thoáng cho không gian sống của chúng ta. Một chiếc gương sáng bóng luôn mang lại cảm giác dễ chịu, tự tin cho mọi thành viên trong gia đình.
Đừng ngại thử nghiệm các phương pháp đã được hướng dẫn. Bạn sẽ thấy, với một chút kiên trì và áp dụng đúng phương pháp, việc đánh bay mọi vết ố, làm gương sáng bừng trở lại không hề khó chút nào. Hãy biến việc vệ sinh gương thành một thói quen đơn giản nhưng mang lại hiệu quả bất ngờ, giúp ngôi nhà của bạn luôn tinh tươm và rạng rỡ!

